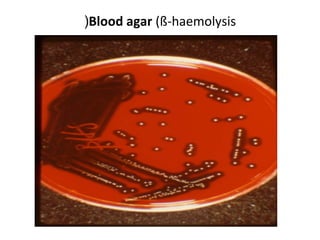
(Blood agar (ß-haemolysis
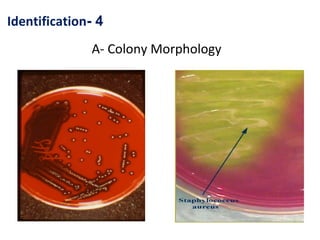
Identification- 4
A- Colony Morphology

1. Staphylococci are gram-positive cocci that grow in clusters and are catalase-positive. The coagulase test is used to differentiate Staphylococcus aureus from coagulase-negative staphylococci (CoNS).
2. S. aureus causes a variety of diseases including localized skin infections, pneumonia, bacteremia, osteomyelitis, endocarditis and toxic shock syndrome. Identification involves culture, microscopy, and biochemical tests like coagulase and catalase.
3. Strain typing methods are used to trace outbreak sources and identify toxin-producing strains causing food poisoning and toxic shock syndrome.